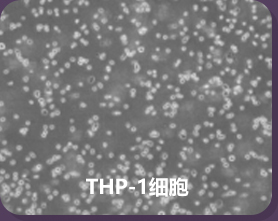
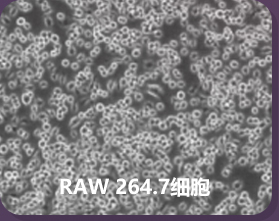

当家明星产品,提供骨髓、脂肪、脐带、脐血、牙髓来源间充质干细胞,来源丰富;
代次低,状态良好,具有良好的增殖能力和分化潜能,多篇客户引用文献支持;
专研各类细胞培养体系,含血清或无血清、多向诱导分化、去外泌体培养,效果验证出色。






订购一株细胞,即送一瓶配套的200mL即用型细胞培养基。购买多株细胞,可叠加享受赠送培养基优惠。
(可选细胞产品范围:赛业OriCell®间充质干细胞、荧光标记的间充质干细胞、细胞系、星形胶质细胞、人成纤维细胞、脐静脉内皮细胞等)。